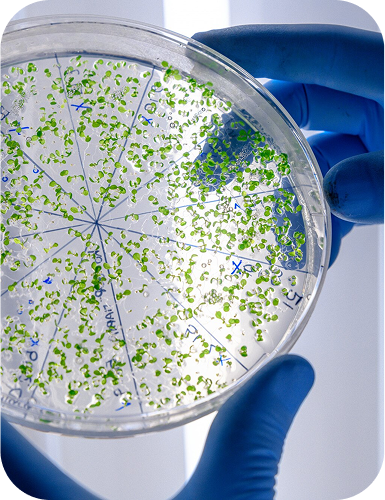
imagen 74

Productos
Optimiza la gestión de enmiendas orgánicas
Ofrecemos productos especializados para mejorar la fermentación y el tratamiento de purines. Nuestra tecnología basada en biotecnología ayuda a reducir olores, potenciar la fertilidad del suelo y optimizar los procesos de gestión en explotaciones ganaderas. Descubre nuestras soluciones y lleva tu producción al siguiente nivel.

Consorcio de bacterias heterolácticas
Microorganismos diseñados para mejorar la estabilidad y eficiencia en la fermentación del purín. Garrafa de 20 litros. Preparación: mezclar la garrafa de 20 litros con 2 litros de leche y 200 litros de agua sin cloro. Suficiente para 200 metros cúbicos de fosa del purín.
40,00 €

Controlador de la fermentación heteroláctica
Minimiza olores, optimiza la descomposición y potencia la calidad del estiércol tratado. Aplicación: 1 litro por cada 5 m3 de purín.
4,00 €

Promotor de la fermentación heteroláctica
Estimula un proceso fermentativo más eficiente y reduce la pérdida de nutrientes esenciales. Modo de aplicación: Esparcir directamente sobre la parrilla o pasillo de las vacas.
75,00 €

Ambientador para las granjas
(Captura de NH4, H2S, CO2, etc.). 1 ambientador con soporte. Suficiente para 10 unidades de ganado mayor.
36,30 €

Fertilizante orgánico granular
(3 % N, 3 % P, 3 % K)

Equipo de procesamiento del purín
Con capacidad de separación sólido-líquido completa, compostaje, y granulación de la enmienda orgánica.
605,00 €